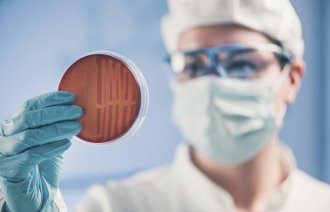
Bildet viser en forsker som holder en petriskål.

Flere barn og eldre får alvorlig streptokokk A-infeksjon

De siste to vintrene er det meldt om stor økning av alvorlig streptokokk A-infeksjoner i Norge. Barn under 10 år og eldre over 70 år har vært spesielt rammet.
– Alvorlig streptokokk A-infeksjon er en sjelden tilstand, men det er grunn til bekymring over den pågående økningen, spesielt hos barn og eldre. Det trengs mer forskning for å forstå hva som forårsaker disse forandringene og identifisere effektive folkehelsetiltak, sier lege Yngvild E. Bentdal ved Folkehelseinstituttet (FHI).
Årsaken til økningen er ikke klar, men en hypotese er at smitteverntiltakene under pandemien førte til færre infeksjoner, og dermed fikk ikke immunforsvaret trent seg like godt på å bekjempe infeksjoner, forklarer Bentdal.
Hun påpeker at det også generelt er høyere risiko for alvorlige bakterieinfeksjoner etter virusinfeksjoner som vannkopper, influensa og RSV.
Kraftig økning
– Når det er mye virusinfeksjoner, som det ofte er i vintersesongen, vil derfor også antallet streptokokk A-infeksjoner kunne øke, sier Bentdal.
Streptokokk A-infeksjon er en av de vanligste årsakene til bakterieinfeksjoner hos mennesker, og de fleste infeksjonene er milde, slik som halsbetennelse.
Men i sjeldne tilfeller kan infeksjonene utvikle seg til alvorlige tilstander som blodforgiftning, toksisk sjokk med organsvikt eller infeksjon med såkalte kjøttetende bakterier, ifølge FHI.
I perioden før pandemien var det i snitt 230 tilfeller som ble rapportert inn til FHI. Til sammenlikning var det i snitt kun 101 tilfeller under pandemien.
I slutten av pandemien, fra mars 2022 til februar i fjor, var det imidlertid 243 tilfeller, fulgt av en stor økning til 553 tilfeller mellom mars 2023 og februar i år.
Barn og eldre rammet
Forekomsten er høyest blant barn under 10 år og eldre over 70 år, ifølge FHI.
Sent i pandemien og etter pandemien utgjorde barna hele 15–20 prosent av alle tilfellene med alvorlig streptokokk A, sammenliknet med kun 9 prosent før pandemien.
Personer over 70 år ble også rammet hardere enn andre aldersgrupper etter pandemien, med flest tilfeller rapportert i januar 2024.

0 Kommentarer